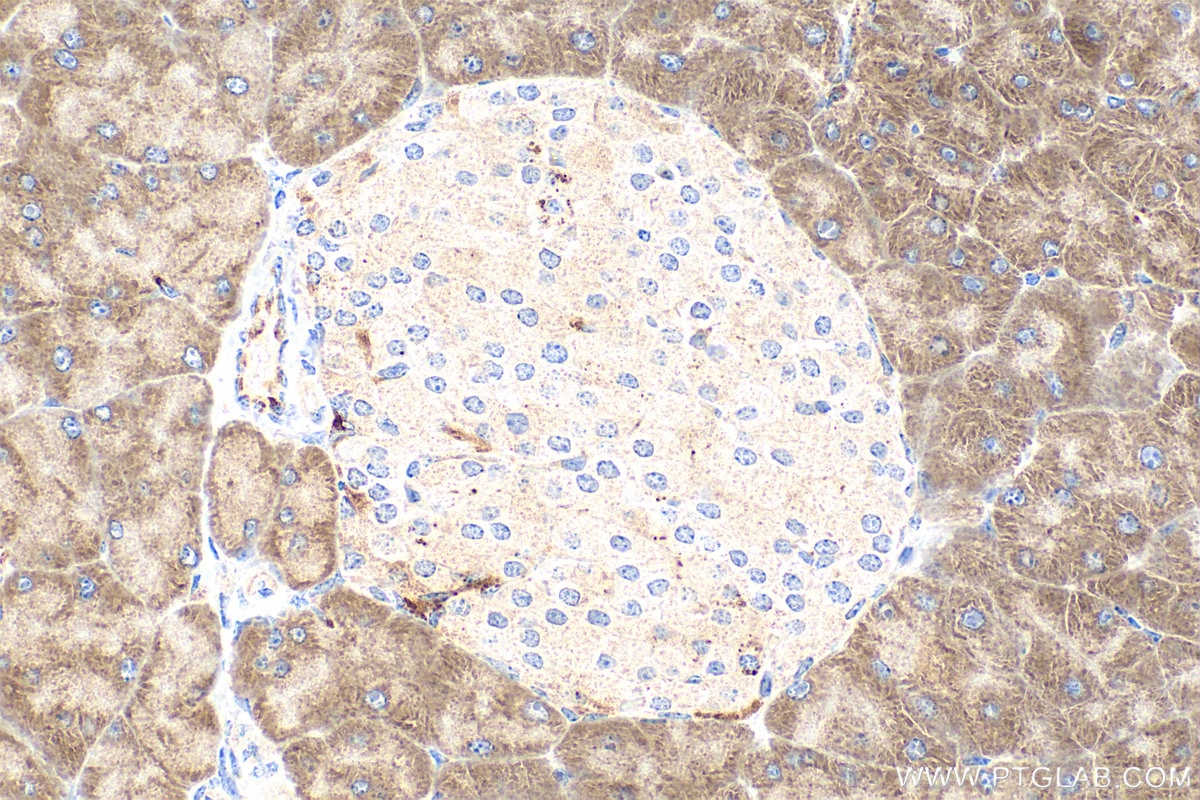
Immunohistochemistry (IHC) staining of mouse pancreas tissue using MNK1 Polyclonal antibody (10136-1-AP)

Tested Applications
| Positive WB detected in | HeLa cells, HEK-293 cells, HepG2 cells, HL-60 cells, mouse small intestine tissue |
| Positive IHC detected in | mouse pancreas tissue Note: suggested antigen retrieval with TE buffer pH 9.0; (*) Alternatively, antigen retrieval may be performed with citrate buffer pH 6.0 |
| Positive IF/ICC detected in | HepG2 cells |
Recommended dilution
| Application | Dilution |
|---|---|
| Western Blot (WB) | WB : 1:500-1:1000 |
| Immunohistochemistry (IHC) | IHC : 1:50-1:500 |
| Immunofluorescence (IF)/ICC | IF/ICC : 1:50-1:500 |
| It is recommended that this reagent should be titrated in each testing system to obtain optimal results. | |
| Sample-dependent, Check data in validation data gallery. | |
Published Applications
| WB | See 3 publications below |
Product Information
10136-1-AP targets MNK1 in WB, IHC, IF/ICC, ELISA applications and shows reactivity with human, mouse, rat samples.
| Tested Reactivity | human, mouse, rat |
| Cited Reactivity | human, mouse |
| Host / Isotype | Rabbit / IgG |
| Class | Polyclonal |
| Type | Antibody |
| Immunogen |
CatNo: Ag0184 Product name: Recombinant human MKNK1 protein Source: e coli.-derived, PGEX-4T Tag: GST Domain: 299-465 aa of BC002755 Sequence: PPFVGHCGADCGWDRGEVCRVCQNKLFESIQEGKYEFPDKDWAHISSEAKDLISKLLVRDAKQRLSAAQVLQHPWVQGQAPEKGLPTPQVLQRNSSTMDLTLFAAEAIALNRQLSQHEENELAEEPEALADGLCSMKLSPPCKSRLARRRALAQAGRGEDRSPPTAL Predict reactive species |
| Full Name | MAP kinase interacting serine/threonine kinase 1 |
| Calculated Molecular Weight | 51 kDa |
| Observed Molecular Weight | 51 kDa, 47 kDa |
| GenBank Accession Number | BC002755 |
| Gene Symbol | MNK1 |
| Gene ID (NCBI) | 8569 |
| RRID | AB_2250527 |
| Conjugate | Unconjugated |
| Form | Liquid |
| Purification Method | Antigen affinity purification |
| UNIPROT ID | Q9BUB5 |
| Storage Buffer | PBS with 0.02% sodium azide and 50% glycerol, pH 7.3. |
| Storage Conditions | Store at -20°C. Stable for one year after shipment. Aliquoting is unnecessary for -20oC storage. 20ul sizes contain 0.1% BSA. |
Background Information
MNK1 (mitogen-activated protein kinase-interacting kinase 1) was discovered as a consequence of bacterial expression libraries screening for proteins regulated by the classical mitogen-activated protein kinases, the ERKs (extracellular signal-regulated kinases). Phosphorylation of Mnk1 has been shown to activate its kinase activity as well as to enhance its binding to the eukaryotic initiation factor 4G (eIF4G) which functions as a scaffolding protein. Human MNK1 arises from an alternatively spliced transcript giving rise to 2 isoforms, longer MNK1a (50 kDa) and a shorter MNK1b variant (38 kDa) that lacks 89 C-terminal amino acids(PMID: 21406405).
Protocols
| Product Specific Protocols | |
|---|---|
| IF protocol for MNK1 antibody 10136-1-AP | Download protocol |
| IHC protocol for MNK1 antibody 10136-1-AP | Download protocol |
| WB protocol for MNK1 antibody 10136-1-AP | Download protocol |
| Standard Protocols | |
|---|---|
| Click here to view our Standard Protocols |
Publications
| Species | Application | Title |
|---|---|---|
Int J Mol Sci Novel HSP90-PI3K Dual Inhibitor Suppresses Melanoma Cell Proliferation by Interfering with HSP90-EGFR Interaction and Downstream Signaling Pathways. | ||
J Enzyme Inhib Med Chem Design, synthesis and molecular mechanisms of novel dual inhibitors of heat shock protein 90/phosphoinositide 3-kinase alpha (Hsp90/PI3Kα) against cutaneous melanoma. | ||
Chem Biol Drug Des Caffeic acid-grafted chitooligosaccharides downregulate MAPK and NF-kB in RAW264.7 cells |